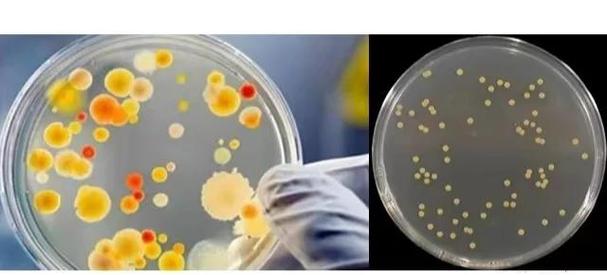

本篇文章给大家谈谈品红亚硫酸钠培养基适用性检查,以及品红亚硫酸钠培养基属于什么培养基对应的知识点,希望对各位有所帮助,不要忘了收藏本站喔。
什么叫指示微生物?
指示性食物的管理意义是反映食物卫生情况。经查询指示性食物主要指菌类,又名指示菌,指示菌是在常规卫生监测中,用来反映食物卫生情况的指示性微生物。食品污染常用的指示菌有菌落总数,代表食品中细菌污染的数量,不仅可作为食品清洁状态的标志,还可以用来预测食品耐储存的期限。
(图片来源网络,侵删)
生物指示物,作为特定灭菌过程的测试系统,包含活微生物,具备特定抗力。其应用范围广泛,主要用于确认灭菌设备性能、验证灭菌程序以及监控生产过程中的灭菌效果。生物指示物依据结构特性可分为普通式与自含式两大类。
生物指示物是具有特定抗力的测试系统,含有活微生物,用于确认灭菌设备性能、验证灭菌程序和监控生产过程中的灭菌效果。它们按照结构特性分为普通式和自含式,按用途分为针对环氧乙烷、湿热、干热、低温蒸汽甲醛、过氧化氢、辐射等不同灭菌方法的生物指示物。
大肠菌在品红亚硫酸钠培养基上的典型特征是怎么样的
观察结果:挑出符合下列特征菌落进行革兰氏染色、镜检。紫红色,具有金属光泽的菌落。深红色,不带或略带金属光泽的菌落。淡红色,中心色较深的菌落。
(图片来源网络,侵删)
亚硫酸钠:能将碱性品红还原,使其褪色。在细菌发酵乳糖产生乙醛时,亚硫酸钠与乙醛和碱性品红结合,生成红色菌落。综上所述,品红亚硫酸钠培养基通过特定的成分和原理,实现了对水中大肠菌群的有效分离和确证,是微生物学实验中常用的培养基之一。
此外,亚硫酸钠能将碱性品红还原,使其褪色,从而更清晰地观察到红色菌落的形成。在使用品红亚硫酸钠培养基进行大肠菌群检测时,首先将适量的培养基倒入无菌培养皿中,待其凝固后,将待测水样均匀涂布于培养基表面。然后,将培养皿倒置放入恒温培养箱中,在适宜的温度下培养一段时间。
化学反应:亚硫酸钠能将碱性品红还原,使其褪色。发酵乳糖的细菌产生的乙醛,与亚硫酸钠和碱性品红反应,生成红色菌落。配方 主要成分:每升培养基中包含10克蛋白胨、5克酵母膏粉。综上所述,品红亚硫酸钠培养基通过特定的化学反应和营养成分,实现对水中大肠菌群的分离或确证试验。
(图片来源网络,侵删)
浅红色。干燥培养基呈紫色粉末状态,品红亚硫酸钠培养基高温灭菌后的颜色为浅红色,品红亚硫酸钠培养基检验原理:蛋白胨、酵母膏粉、牛肉膏粉提供碳氮源、维生素和矿物质:乳糖为可发酵的糖类。
大肠菌群一般包括大肠埃希氏杆菌、产气杆菌、枸椽酸杆菌和副大肠杆菌。大肠菌群的各类菌的生理习性都相似,只是副大肠杆菌分解乳糖缓慢,甚至不能分解乳糖,并且它们在品红亚硫酸钠培养基(远藤氏培养基)上所形成的菌落不同。
大肠杆菌群包括哪些种类的细菌?它们的习性如何?
细胞壁结构是细菌分类的另一个重要依据,细菌据此被分为革兰氏阳性菌和革兰氏阴性菌。革兰氏阳性菌包括葡萄球菌、链球菌、肺炎双球菌、炭疽杆菌、白喉杆菌和破伤风杆菌等,这些细菌能产生外毒素;革兰氏阴性菌如大肠杆菌和伤寒杆菌,它们产生内毒素。根据致病性,细菌可以分为条件性致病菌和非致病菌。
阿扑西林的抗菌谱主要包括以下几类细菌:革兰氏阳性菌:葡萄球菌属:包括多种能引起化脓性感染的葡萄球菌。链球菌属:包括多种能引起咽炎、扁桃体炎、肺炎等疾病的链球菌。肺炎球菌:是引起肺炎、脑膜炎等疾病的重要病原体。
高一生物蓝细菌包括:大肠杆菌、乳酸菌、链球菌、葡萄球菌等。细菌是生物的主要类群之一,属于细菌域。细菌是所有生物中数量最多的一类,据估计,其总数约有 5×10的三十次方个。细菌的个体非常小,目前已知最小的细菌只有0.2微米长,因此大多只能在显微镜下看到它们。
根据细菌的细胞壁特征,可以将细菌分为革兰氏阳性菌和革兰氏阴性菌。革兰氏阳性菌包括葡萄球菌、链球菌、肺炎双球菌、炭疽杆菌、白喉杆菌、破伤风杆菌等,它们能产生外毒素使人致病;革兰氏阴性菌主要指肠道菌,如大肠杆菌、伤寒杆菌等,它们产生内毒素,靠内毒素使人致病。
定义:没有真正细胞核的微生物,只有拟核结构。特点:细胞核:分化程度较低,无核膜和核仁,仅有原始核。细胞器:很不完善,通常只有核糖体。遗传物质:DNA和RNA同时存在。示例:细菌(如大肠杆菌、金黄色葡萄球菌)、支原体、衣原体、立克次体、螺旋体、放线菌等。
细菌在有氧和无氧环境中生活习性不同。在有氧环境里,好氧细菌能够充分利用氧气进行有氧呼吸,通过氧化有机物来获取能量,代谢效率较高。它们在这种环境下生长繁殖迅速,能够适应相对丰富的氧气供应,将有机物彻底分解为二氧化碳和水等简单无机物。
品红亚硫酸钠培养基适用性检查的介绍就聊到这里吧,感谢你花时间阅读本站内容,更多关于品红亚硫酸钠培养基属于什么培养基、品红亚硫酸钠培养基适用性检查的信息别忘了在本站进行查找喔。
本文可能通过AI自动登载或用户投稿,文章仅代表原作者个人观点。本站旨在传播优质文章,无商业用途。如侵犯您的合法权益请联系删除。